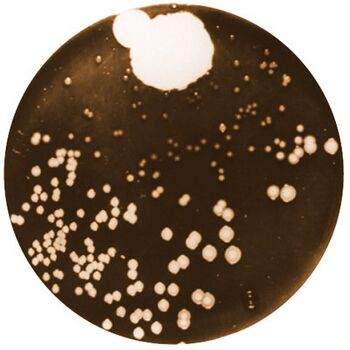
Fleming's original culture plate

Citizen Science/Open Colony Counter Project
From OpenWetWare
Jump to navigationJump to search
<html> <body>
<script type="text/javascript"> var sc_project=4805224; var sc_invisible=1; var sc_partition=54; var sc_click_stat=1; var sc_security="7443ae9c"; </script>
<script type="text/javascript"
src="http://www.statcounter.com/counter/counter.js"></script><noscript>
<a title="visit counter for blogspot"
href="http://www.statcounter.com/blogger/" target="_blank"><img class="statcounter" src="http://c.statcounter.com/4805224/0/7443ae9c/1/"
alt="visit counter for blogspot" ></a></noscript>
</body> </html>
|
Driving forces:
Team:
|
Specifications
Vincent 13:06, 1 August 2010 (EDT): feel free to comment.
Features
- General:
- can detect and count microbial colonies
- accepted plate format: 60-90mm plates or multi-well plate format
- desktop device for the wetlab bench
- requires a PC (windows, osx, or linux)
- Laser-cut design for the casing
- lab automation friendly design
- Open Source design
- Available Measurements:
- colony count
- individual colony properties (size, roundness, position)
- export in CSV format or local database
- PDF/HTML report with overlaid image with detection results + colony statistics
- Image processing:
- one-step processing for the user
- colony count in less than 3 seconds.
- automatic background detection
- utilizes LED illumination to optimize contrast between colonies and substrate.
- possible manual colony count editing for improved count.
- USB Webcam as an image acquisition device
User case: typical use
- the user places his/her plate inside the colony counter
- the user opens the colony counting application on the attached PC
- the user triggers the image acquistion and counting by pressing a single button
- results are displayed as an overlay on the acquired image
- if required, the user can adapt image processing parameters to improve detection
- the user can then export results in various format (CSV, HTML, PDF)
Technological stack under investigation:
- Image acquisition device: USB Webcam-based
- Light source: white LEDs, 470nm LEDs for GFP-like detection
- Image processing engine: OpenCV library
- Laser cut design for the casing
Vincent 13:06, 1 August 2010 (EDT): feel free to comment.